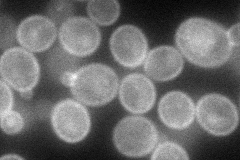
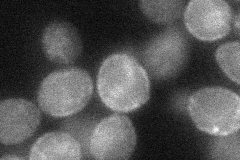
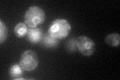

View description
High-affinity cysteine-specific transporter with similarity to the Dal5p family of transporters; green fluorescent protein (GFP)-fusion protein localizes to the endoplasmic reticulum; YCT1 is not an essential gene
Localization:
Intensity:
Fold change:
Significance:
-
C’ GFP library in SD

below threshold18 -
N' NOP1pr-GFP in SD
cell periphery,punctate,vacuole77.9134 -
N' TEF2pr-mCherry in SD

cell periphery,vacuole162.912 -
N' NATIVEpr-GFP in SD

below threshold22.3905 -
N' TEF2pr-VC and Cyto-VN in SD
cell periphery33.4626 -
C’ GFP library in SD+DTT

cytosol15.220.84No -
C’ GFP library in SD+H2O2

cytosol20.161.11No -
C’ GFP library in Starvation Media
ER116.216.45No -
C’ GFP library on the background of Pup2-DaMP

N/A -
C’ GFP library on the background of CCT mutant

N/A0N/AYes
